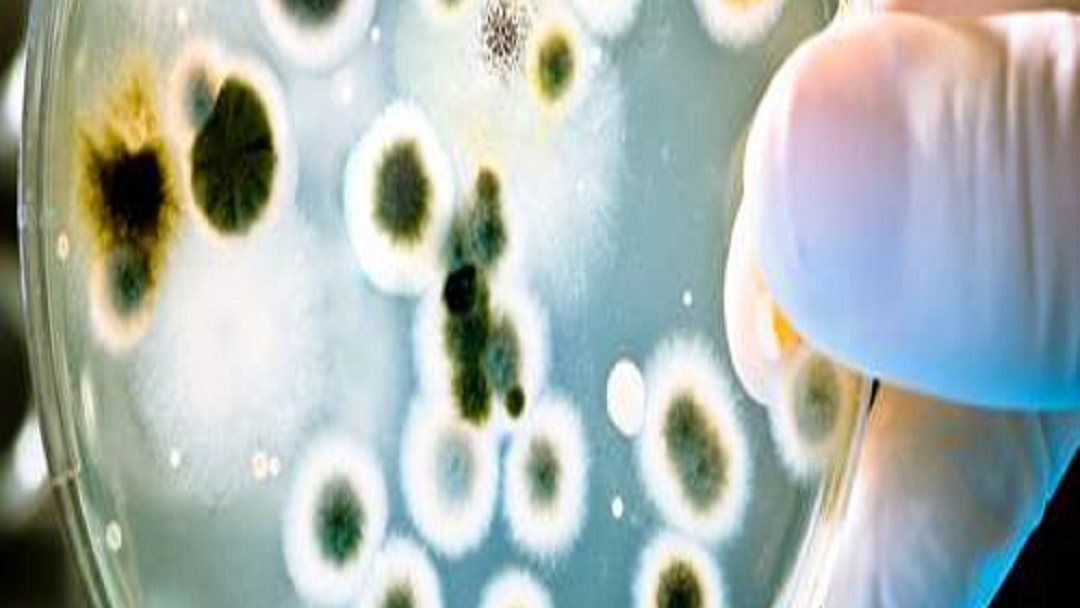
txt

بعد ارتفاع حاد في إصابات كوفيد-19 بشنجهاي الصينية، تسجل العاصمة الصينية بكين اختبارات جماعية لملايين السكان بعد ارتفاع حاد في الإصابات.
ووفقا لهيئة الإذاعة البريطانية، سجلت منطقة تشاويانج 26 حالة خلال عطلة نهاية الأسبوع، وهو أعلى رقم حتى الآن في أحدث زيادة في إصابات بكين.
تم مشاهدة طوابير طويلة خارج محلات السوبر ماركت، والمتاجر، رغم تأكيد الحكومة بوجود طعام كاف، ويأتي ذلك وسط مخاوف من أن تواجه بكين وضعا مماثلا لما حدث في شنغهاي ، التي شهدت إغلاق نحو 25 مليون شخص في منازلهم لأسابيع.
وسيخضع جميع سكان تشاويانج البالغ عددهم 3.5 مليون نسمة، وهي منطقة بكين الأكثر اكتظاظًا بالسكان، فقا لبيانات صادرة عن فريق الوقاية من الأمراض في المدينة.
كانت هذه الاخبار سببا في إسراع السكان لتخزين الإمدادات الأساسية، مع تداول صور على وسائل الإعلام المحلية تظهر أرفف السوبر ماركت فارغة من البضائع وتلتف في طوابير عند مكاتب تسجيل المغادرة.
كما مددت محلات السوبر ماركت الرئيسية في بكين ساعات عملها لاستيعاب الارتفاع في الطلب، وقال أحد مستخدمي تطبيق “ويبو” في شنغهاي: “لم أفكر مطلقًا في أنني سأذهب إلى السوق في الصباح الباكر، عندما وصلت إلى هناك ، اختفت اللحوم والبيض والخضروات”.
وقالت صحيفة “ذا جلوبال تايمز” الإخبارية التابعة للدولة إن شركات الأغذية الطازجة في بكين قد صدرت أوامر لها بزيادة المعروض من محلات البقالة مثل اللحوم وبيض الدواجن والخضروات.
كما نقلوا عن خبراء الصحة قولهم إن نتائج الاختبار الجماعي ستشير إلى ما إذا كانت هناك حاجة إلى مزيد من التدابير، مثل إغلاق عدة مناطق، وقال بانج شينجهو ، نائب مدير مركز بكين للوقاية من الأمراض ومكافحتها، إنه من المتوقع أن يزداد عدد الحالات في بكين في الأيام التالية.
وقد شهد تفشي المرض الأخير في شنغهاي، الذي تم اكتشافه لأول مرة في أواخر مارس، أكثر من 400 ألف حالة إصابة مسجلة حتى الآن و 138 حالة وفاة.
تشمل بعض الإجراءات التي فرضتها السلطات الصينية وضع أجهزة إنذار إلكترونية للأبواب لمنع المصابين من المغادرة وإجلاء الأشخاص من منازلهم لتنفيذ إجراءات التطهير